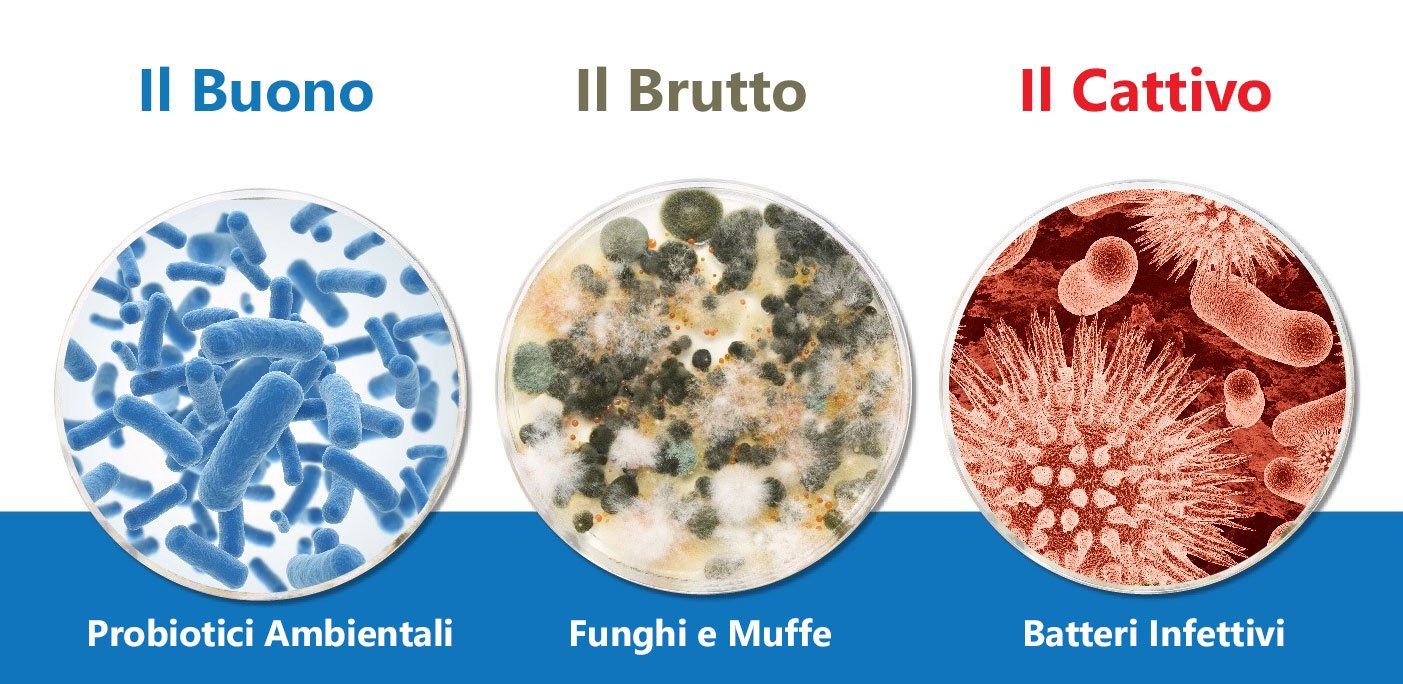
pulizia e sanificazione serbatoio acqua camper

Acqua igienizzata per il tuo Camper
Viaggiare in camper è una delle esperienze più emozionanti, in quanto permette di passare piacevoli momenti di vacanza in tutta tranquillità e comodità. Ma come ogni mezzo di trasporto, anche il camper ha bisogno di manutenzione e soprattutto acqua igienizzata.
Da Ary camper i serbatoi dell'acqua, come tutto l'impianto idrico, vengono igienizzati e sanificati con i prodotti Acquatravel.
L'azienda è leader nel settore trattamento acqua per i mezzi in movimento. Nel 2014 ACQUATRAVEL viene ingaggiata dall'associazione ONG Vento di Terra di Rozzano (Milano) per elaborare un progetto di trattamento acqua potabile per i campi profughi siriani in Giordania, fornendo più di 121 KIT SURVIVOR.
Nel 2016 ha presentato il nuovo filtro “ANTI-LEGIONELLA e ANTI-BATTERI” brevettando un esclusivo metodo di rigenerazione, disinfezione e sanificazione del filtro stesso, creando così un filtro senza “fine” o comunque a lunga durata, superando abbondantemente i 180.000 litri erogati e tutt'ora perfettamente funzionante.
Prodotti in vendita per igienizzare Acqua Camper
Prodotti per l'igienizzazione
- Sanificante igenizzante, che elimina i residui di biofilm, alghe e piccole incrostazioni
- Kit Carico Acqua, per caricare comodamente acqua pulita nel proprio serbatoio
- Filtro a sedimenti Compact, per fermare lo sporco prima che entri nel serbatoio
- Biochlor “Acqua Chiara”, il primo prodotto studiato apposta e già pre-dosato per eliminare la carica batterica nei serbatoi dell’acqua
- Filtro Anti Batteri Legionella
- Smell Stop, pronto intervento conto i cattivi odori
- Filtro Anti Batteri Small + Easy Drink AG, per il controllo batteriologico dell’acqua chiara, senza dover aggiungere additivi chimici
- Legionella Small, che elimina il 99% della carica batterica dall’acqua, compreso il batterio della legionella
- Filtro Anti Batteri + Carbone AG
- Legionella Easy, che elimina il problema dei batteri del camper
- Easy Drink, un filtro che si può installare sotto lavello o direttamente dopo la pompa
- 4×1 Bacterias 10-20 lt/m, un filtro a Carboni Attivi in fibra di cocco addizionato con AG battericida con una filtrazione che può raggiungere i 10 litri di acqua al minuto
- Silver Globe, una piccola sfera da inserire direttamente serbatoio
- Silver Hive
- Dischetto Cleo
- Acquatravel Stone, per eliminare il calcare
- Pulitore righe nere
- Pulitore bagno
- Pulitore moscerini
- Pulitore Tendalini, che elimina tutto lo smog e le resine prodotte dalle piante
- Acquatravel Wash, per eliminare il calcare e i residui
- Carbon Viesa, filtro per condizionatori evaporativi